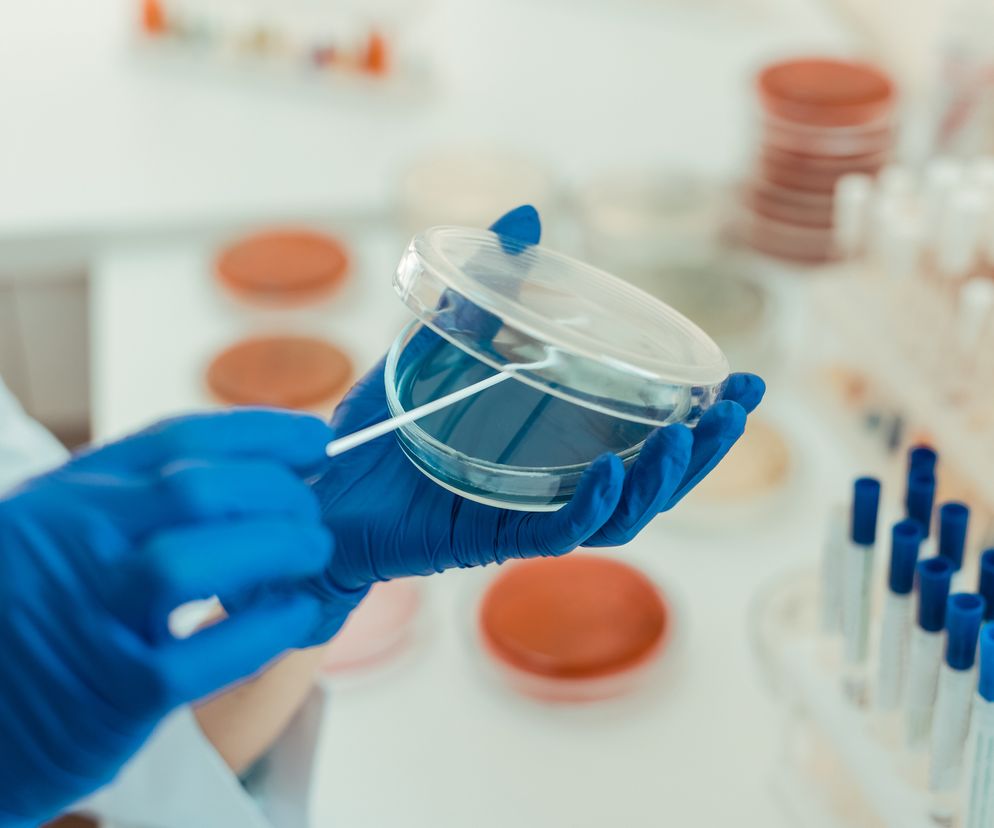
Szalka Petriego

Spis treści
Posiew to badanie mikrobiologiczne wykonywane w celu wykrycia i identyfikacji patogenów w próbkach materiału biologicznego.
Ze względu na rodzaj badanych patogenów, wyróżnia się posiew posiew bakteriologiczny (badanie bakteriologiczne) oraz posiew mykologiczny (badanie mykologiczne).
Ze względu na rodzaj materiału biologicznego, wyróżnia się posiew krwi, moczu, kału, nasienia, plwociny czy wydzieliny z pochwy. Materiałem biologicznym może być także płyn mózgowo rdzeniowy, wymaz z gardła, ucha, nosa, śluzówki jamy ustnej, a nawet z worków spojówkowych oczu, z krost i innych zmian skórnych, a także z ran, przetok czy ropni, itd.
Posiew - wskazania do badania
Posiew wykonuje się w przypadku podejrzenia zakażenia, czyli gdy wystąpią u pacjenta jego objawy. Na przykład wskazaniem do posiewu moczu będą objawy zakażenia układu moczowego, takie jak ból krzyża lub częste i bolesne oddawanie moczu.
Z kolei zakażenie krwi można podejrzewać wtedy, gdy pojawią się gorączka i dreszcze, przyśpieszony oddech i czynność serca, spadek ciśnienia tętniczego, zaburzenia świadomości czy skąpomocz. Natomiast posiew kału wykonuje się u chorego, u którego występują biegunka, skurcze brzucha i/lub obecna jest w kale krew, lub śluz.
Posiew moczu i wydzieliny z pochwy powinno się wykonać u kobiet w ciąży – nawet mimo braku objawów infekcji – aby wykluczyć obecność mikroorganizmów, mogących stanowić zagrożenie dla dziecka.
Czytaj też: Antybiogram przed leczeniem antybiotykiem. Jak wygląda antybiogram i jak czytać jego wyniki?
Posiew - pobranie materiału biologicznego
Najpierw należy odpowiednio pobrać próbkę materiału biologicznego. W przypadku posiewu krwi muszą to być przynajmniej dwie jej próbki pobrane z dwóch różnych żył, do dwóch probówek zawierających dwa rodzaje podłoża hodowlanego (pozwalające na wykrycie zarówno bakterii tlenowych, jak i beztlenowych).
Z kolei materiał biologiczny z pochwy pobiera się specjalną wymazówką - jeden wymaz pobiera się z przedsionka pochwy, a drugi z okolic odbytu. Następnie wymazówki również umieszcza się na specjalnym podłożu (tzw. podłoże transportowe). Natomiast posiewu moczu przeprowadzany jest na próbce pierwszego mocz po nocy (wówczas ilość bakterii jest największa), który zostaje pobrany do jałowego pojemnika metodą tzw. środkowego strumienia.
Przed wykonaniem posiewu należy poinformować lekarza o wszystkich przyjmowanych lekach (szczególnie antybiotykach i lekach wpływających na krzepnięcie krwi), schorzeniach oraz o ewentualnym nosicielstwie patogenów przenoszonych przez krew (np. HBV, HCV, HIV).
Posiew - na czym polega badanie?
ETAP 1 - POSIEW
Pierwszym etapem jest posiew materiału biologicznego, tzn. naniesienie próbki materiału na tzw. podłoże hodowlane (mikrobiologiczne). Jest to mieszanina odpowiednio dobranych składników odżywczych, pozwalających na wzrost i namnażanie się mikroorganizmów. Najpowszechniej stosowane są podłoża wzrostowe, które są wzbogacone krwią, ponieważ zapewniają optymalne warunki do wzrostu większości gatunków patogenów.
Posiew można wykonać na kilka sposobów: na podłożu płynnym, na skosie agarowym, jednak najczęściej wykonuje się go na płytkach Petriego (to naczynie laboratoryjne, cylindryczna podstawka o szerokim, płaskim dnie), tzn. odrobinę badanego materiału rozprowadza się zygzakiem lub promieniście na całej powierzchni podłoża lub też dzieli się je na sektory i w nich rozprowadza się materiał.
Posiewu dokonuje się zwykle pod komorą laminarną, która pozwala na zachowanie jałowych warunków. Komora chroni przed wniknięciem do komory bakterii czy zarodników grzybów, które stale unoszą się w powietrzu poza komorą.
Tak się postępuje np. w przypadku posiewu moczu. W przypadku posiewu krwi ten etap jest ominięty, ponieważ pożywki są wprowadzone do sterylnych butelek lub probówek, do których bezpośrednio jest pobierana krew. Podobnie w przypadku wymazów, które bezpośrednio po pobraniu są umieszczone na specjalnym podłożu i od razu przeznaczone do hodowli.
ETAP 2 - HODOWLA
Po naniesieniu próbki na podłoże umieszcza się ją w cieplarce, gdzie panuje temperatura odpowiadającej temperaturze ludzkiego ciała. Są to bowiem warunki doprowadzające do namnażania się mikroorganizmów. Stymulację wzrostu pożądanych mikroorganizmów można uzyskać również poprzez dobór odpowiedniego pH oraz natlenienie. Hodowla patogenów trwa od 24-48 godzin (niektóre gatunki bakterii) do nawet kilkudziesięciu dni (niektóre grzyby).
ETAP 3 - IZOLACJA
Celem tego etapu jest izolacja określonego gatunku patogenu. W przypadku wyizolowania drobnoustrojów wykonywana jest zawiesina bakteryjna o określonej gęstości, która zostanie wykorzystana w celu identyfikacji i oznaczenia lekowrażliwości szczepu.
ETAP 4 - IDENTYFIKACJA
Obecnie do identyfikacji drobnoustrojów stosuje się testy biochemiczne, manualne lub automatyczne. Przykładem testu biochemicznego jest test API. Polega on na wprowadzeniu zawiesiny bakteryjnej do każdej z mikroprobówek znajdujących się w zestawie. Kolejnym etapem jest hodowla drobnoustrojów w odpowiedniej temperaturze. Reakcje biochemiczne, które zachodzą w tym czasie, powodują zmiany zabarwienia, powstałe samoistnie lub po dodaniu odczynnika wskaźnikowego. Do odczytu służy książka kodowa lub specjalny program komputerowy.
Uzupełniłem diagnostyki mikrobilogicznej jest preparat mikroskopowy, który daje możliwość obserwacji komórek patogenu po wcześniejszym ich zabarwieniu.
ETAP 5 - ANTYBIOGRAM
Po zakończeniu posiewu wykonuje się antybiogram, którego celem jest ocena wrażliwości patogenu na lek. Na odpowiednim podłożu z naniesioną zawiesiną bakteryjną mikrobiolog umieszcza krążki z antybiotykami o określonych stężeniach (tzw. antybiogram). Odczytu antybiogramu dokonuje się w oparciu o mierzenie wielkości stref zahamowania wzrostu wokół krążków z antybiotykiem.
Na podstawie wyników badania mikrobiologicznego i antybiogramu lekarz podejmuje decyzję o wyborze odpowiedniego leczenia.
Polecany artykuł: